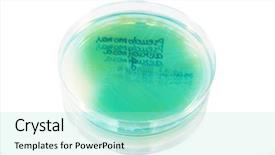
Presentation with white plate - Cool new presentation with petri plate with bacteria pseudomonas backdrop and a arctic colored foreground

694 Best White Plate-Themed Templates for PowerPoint and Google Slides
Experience the warmth and elegance of fine dining with our exquisite White Plate PowerPoint templates. Inspired by the sophistication of award-winning restaurants and the hospitality of top-notch establishments, these stunning slides will elevate your presentations to new heights.
Our White Plate collection is designed to transport you to a world of refined luxury, where every detail is carefully crafted to inspire awe. With its elegant backdrop and delicate design elements, this template is perfect for showcasing your creativity and flair. Whether you're sharing the success story of your latest venture or highlighting the culinary expertise of a renowned chef, our White Plate templates are sure to impress.
With our comprehensive collection spanning 60+ slides, you'll have endless options to suit any presentation style or theme. Easily browse through the category by title, from Pepper and Cheese Sandwich on White Plate to Table Set with Vegetables, Onions, Carrot and Grilled Meat, each slide offering a unique visual identity that will delight your audience.
At CrystalGraphics, we're committed to delivering top-notch templates that meet the highest standards of quality and usability. Our White Plate collection is designed to be easily customized with full personalization options, ensuring that you can tailor it to your specific needs. Plus, with instant 24/7 download access, you'll have access to these incredible templates at your fingertips.
So why wait? Explore our extensive collection today and discover the perfect template for your next presentation. Browse through other categories or select the perfect White Plate slide set for your needs. Download and customize with ease we've got you covered!
Features & Pricing
Widescreen (16:9) Presentation Templates. Change size...